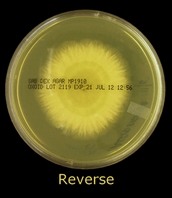

Gliocladium species(Fungus)
Ecology & Pathogenicity:
Gliocladium is a cosmopolitan fungus which can be isolated from soils as well as decaying plant material (saprobe). Gliocladium is considered to be a contaminant when found in the clinical situation as no cases of human or animal infections have been documented.
Colony Morphology:
Gliocladiumexhibits rapid growth, maturing within 4 to 5 days. Surface growth is white to cream at first but quickly develops various shades of green. The outer fringe may remain white. Some strains may also exhibit pink colouration on the surface. Surface texture has been described as cottony to woolly. Reverse is unremarkable, pale or slightly yellow in colour.
Gliocladium species on SAB at 72hrs, 30oC
Gliocladium produces hyaline (clear/non-pigmented), septate hyphae. Extending from the hyphae are conidiophores which branch in the upper portion somewhat resembling Penicillium species. Extending from the branching conidiophores are somewhat ‘flask-shaped’ phialides which are arranged in brush-like clusters at the apices. The unicellular conidia produced by the phialides are smooth walled and ovoid in shape. Conidia do not chain but rather accumulate at the apex of each individual conidiophore as a rather large slimy ball.
* * *
Gliocladium sp. on Slide Culture (X100 LPCB: DMD-108)
Gliocladium sp. -'balls' of conidia visible at top of phialides
(X400 LPCB: DMD-108)
Gliocladium sp. (X400+10* LPCB: DMD-108)
Gliocladium sp. - yet another view of hyphae, conidiophores, phialides & balls of conidia
(X400+10* LPCB: DMD-108)
Gliocladium sp. - and another view as above.
(X400+10* LPCB: DMD-108)
Gliocladium sp. - a few phialides without conida shows there somewhat "flask-like" or "inflated" shape. (X400 LPCB: DMD-108)
Gliocladium sp. a good view of a conidiophore from which extend the brush-like phialides which produce the conidia. (X400+10* LPCB: DMD-108)
Gliocladium sp. This photo better shows what have been described as "flask-shaped" phialides
(X400+10* LPCB: DMD-108)
Gliocladium sp. -As above but a closer view.
(X1000+10* LPCB: DMD-108)
Gliocladium sp. -More is better! Another view to get a feel of what the phialides look like.
(X1000+10* LPCB: DMD-108)
Gliocladium sp. -a good shot of the brush-like phialides extending from the conidiophore and the "sticky" ball of conidia which have formed at the tips of the phialides but because of their stickiness, have remained together at the apex. (X1000+10* LPCB: DMD-108)
Gliocladium sp. -Taking a step back, this photo shows the branching conidiophore, each bearing the brush-like 'Penicillate' phialides and ball of conida. (X400 LPCB: DMD-108)
Gliocladium species (X1000+10* LPCB: DMD-108)
Gliocladium species (X1000+10* LPCB: DMD-108)
Gliocladium species -large collection of conidia at apex of phialides
(X1000+10* LPCB: DMD-108)
Gliocladium species - Intended as computer wallpaper (1024X768 when posted)
* The DMD (Digital Micro imaging Device) is capable of adding an additional 10% digital magnification to the optical magnification of the objectives